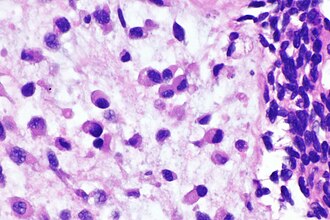

Plasmacytoid urothelial carcinoma
(Redirected from Plasmacytoid UCC)
Jump to navigation
Jump to search
| Plasmacytoid urothelial carcinoma | |
|---|---|
| Diagnosis in short | |
Plasmacytoid urothelial carcinoma | |
|
| |
| Synonyms | plasmacytoid urothelial cell carcinoma, plasmacytoid variant of urothelial carcinoma |
|
| |
| LM | plasmacytoid morphology (abundant gray cytoplasm; eccentrically placed (usually round) nucleus), +/-mucous (common), usually with conventional urothelial carcinoma |
| Subtypes | subtype of urothelial carcinoma |
| LM DDx | plasma cell neoplasm, signet ring cell carcinoma, mucinous adenocarcinoma, invasive lobular carcinoma |
| IHC | AE1/AE3 +ve, EMA +ve, CK7 +ve, CK20 +ve, CD138 +ve, p63 +ve/-ve |
| Molecular | CDH1 loss of function mutations |
| Grossing notes | radical cystectomy grossing, cystoprostatectomy grossing, nephroureterectomy grossing |
| Staging | bladder cancer staging |
| Site | urothelium |
|
| |
| Signs | +/-hematuria |
| Prevalence | rare |
| Prognosis | poor |
| Treatment | surgical excision, chemotherapy |
Plasmacytoid urothelial carcinoma, also plasmacytoid urothelial cell carcinoma and plasmacytoid variant of urothelial carcinoma, is a rare aggressive variant of urothelial carcinoma.
General
Features:[1]
- Aggresive.
- Uncommon.
- Often associated with positive margins (relative to other urothelial carcinoma variants); spreads along fascial planes.[2]
Microscopic
Features:
- Plasmacytoid morphology:
- Abundant gray cytoplasm.
- Eccentric nucleus - usually round, occasionally crescentic.
- +/-Mucous (common).
DDx:
- Plasma cell neoplasm.
- Signet ring cell carcinoma.
- Mucinous adenocarcinoma.
- Invasive lobular carcinoma of the breast.
Images
www:
IHC
Features:[3]
- AE1/AE3 +ve (16 +ve/16 cases).
- EMA +ve (16 +ve/16 cases).
- CK7 +ve (16 +ve/16 cases).
- CK20 +ve (16 +ve/16 cases).
- CD138 (15 +ve/16 cases).
- p63 (11 +ve/16 cases).
Others:
- E-cadherin -ve (0 positive of 4 cases[4]).
- HER2 +ve/-ve.
Molecular
- CDH1 loss of function - common.[7]
Sign out
Urinary Bladder Tumour, Transurtheral Resection: - INVASIVE HIGH-GRADE UROTHELIAL CARCINOMA with plasmacytoid morphology. -- Invasion into the muscularis propria. -- Please see tumour summary.
See also
References
- ↑ Qin, M.; Wang, G.; Sun, Y.; He, Q.. "Plasmacytoid urothelial carcinoma of the bladder.". Indian J Pathol Microbiol 57 (2): 320-2. doi:10.4103/0377-4929.134730. PMID 24943778.
- ↑ Kaimakliotis, HZ.; Monn, MF.; Cheng, L.; Masterson, TA.; Cary, KC.; Pedrosa, JA.; Foster, RS.; Koch, MO. et al. (May 2014). "Plasmacytoid bladder cancer: variant histology with aggressive behavior and a new mode of invasion along fascial planes.". Urology 83 (5): 1112-6. doi:10.1016/j.urology.2013.12.035. PMID 24582117.
- ↑ Zhang, W.; Jiang, YX.; Liu, Y.; Yu, WJ.; Zhao, H.; Li, YJ. (Jul 2013). "[Plasmacytoid urothelial carcinoma of the urinary bladder: a clinicopathologic study of 16 cases].". Zhonghua Bing Li Xue Za Zhi 42 (7): 433-7. PMID 24246859.
- ↑ Lim, MG.; Adsay, NV.; Grignon, DJ.; Osunkoya, AO. (Feb 2011). "E-cadherin expression in plasmacytoid, signet ring cell and micropapillary variants of urothelial carcinoma: comparison with usual-type high-grade urothelial carcinoma.". Mod Pathol 24 (2): 241-7. doi:10.1038/modpathol.2010.187. PMID 20818341.
- ↑ Kim, B.; Kim, G.; Song, B.; Lee, C.; Park, JH.; Moon, KC. (2016). "HER2 Protein Overexpression and Gene Amplification in Plasmacytoid Urothelial Carcinoma of the Urinary Bladder.". Dis Markers 2016: 8463731. doi:10.1155/2016/8463731. PMID 27034533.
- ↑ Bellmunt, J.; Werner, L.; Bamias, A.; Fay, AP.; Park, RS.; Riester, M.; Selvarajah, S.; Barletta, JA. et al. (Jun 2015). "HER2 as a target in invasive urothelial carcinoma.". Cancer Med 4 (6): 844-52. doi:10.1002/cam4.432. PMID 25720673.
- ↑ Al-Ahmadie, HA.; Iyer, G.; Lee, BH.; Scott, SN.; Mehra, R.; Bagrodia, A.; Jordan, EJ.; Gao, SP. et al. (Feb 2016). "Frequent somatic CDH1 loss-of-function mutations in plasmacytoid variant bladder cancer.". Nat Genet. doi:10.1038/ng.3503. PMID 26901067.






